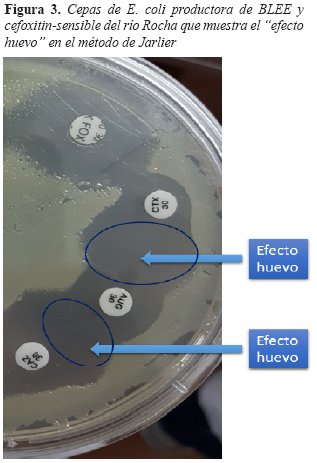

Services on Demand
Journal
Article
Indicators
-
 Cited by SciELO
Cited by SciELO -
 Access statistics
Access statistics
Related links
-
 Similars in
SciELO
Similars in
SciELO
Share
Revista Científica Ciencia Médica
Print version ISSN 2077-3323
Rev Cient Cienc Méd vol.22 no.2 Cochabamba 2019
Artículo Original
ENTEROBACTERIAS PRODUCTORAS DE B-LACTAMASAS DE ESPECTRO-EXTENDIDO Y PLÁSMIDO-AMPC EN AGUAS DE RIEGO, ZONA MAICA, COCHABAMBA
EXTENDED-SPECTRUM B-LACTAMASE AND PLASMID AMPC B-LACTAMASE-PRODUCING ENTEROBACTERIACEAE IN WATER SOURCES FOR IRRIGATION IN MAICA'S ZONE, COCHABAMBA
Raul Andres Flores Moya1, Claudia Susana Albornoz Cardozo1, Jhera Hurtado Cáceres1, Vanessa Massiel Montaño Villagomez1, Dra. Adriana Santa Cruz2
1Estudiante de la Facultad de Medicina "Dr. Aurelio Melean" carrera de medicina de la Universidad Mayor de San Simón
2Master en Bacteriología. Docente de la materia de Bacteriología en Facultad de Medicina "Dr. Aurelio Melean" de la Universidad Mayor de San Simón
Correspondencia a: Raul Andres Flores Moya
Correo: raulandresfloresmoya@gmail.com
Teléfono y celular: 4219317-+59165300730
Procedencia y arbitraje: no comisionado, sometido a arbitraje externo.
Recibido para publicación: 20 de marzo de 2019
Aceptado para publicación: 16 de noviembre de 2019
Citar como: Flores R, Albornoz C, Hurtado J, Montaño V, Santa Cruz A. Enterobacterias productoras de B-lactamasas de espectro-extendido y plásmido-AmpC en aguas de reigo, zona Maica, Cochabamba. Rev Cient Cienc Med 2019;22(2): 15-21
RESUMEN
Introducción: Las enterobacterias han ido adquiriendo mecanismos de resistencia a los antimicrobianos, como la producción de Beta Lactamasas de Espectro Extendido (BLEE) que otorga resistencia a varios beta-lactámicos. Estas bacterias, capaces de causar infecciones intrahospitalarias y comunitarias difíciles de tratar, se están diseminando y habitan reservorios ambientales, como aguas;y es considerado un problema de salud pública. Situación desconocida en nuestro medio. Objetivo: Identificar Enterobacterias productoras de BLEE y AmpC en agua de los ríos Tamborada y Rocha, utilizados para el riego de cultivos en la zona Maica de Cochabamba. Métodos: Estudio descriptivo, transversal y cuantitativo. Se analizaron 70 muestras de agua: 44 del rio Tamborada y 26 del Rocha. Las muestras se cultivaron en Agar MacConkey con Cefotaxima (2 μm/ml). Las bacterias que crecieron se identificaron con agar cromogénico y pruebas bioquímicas. Las cepas productoras de BLEE y tipo AmpC se determinaron por difusión y aproximación de discos: Cefotaxima, ceftazidima, Amoxicilina/Acido clavulánico para BLEE y Cefoxitin para AmpC. Resultados: Se aislaron 23 cepas de Escherichia coli (E. coli) productoras de BLEE (32,8%) de las 70 muestras y 22 muestras (resistentes a cefoxitin) que podrían tener además resistencia tipo AmpC. Conclusión: E. coli productoras de BLEE y probablemente AmpC están circulando en ambientes de nuestro medio como ser agua de Ríos Tamborada y Rocha, esto representa un problema de salud pública, más si consideramos que estas aguas son utilizadas en riego de verduras que abastecen los mercados de Cochabamba y pueden diseminar estas bacterias entre la población.
Palabras clave: Enterobacteriaceae, beta-Lactamasas, Aguas Residuales, Riego Agrícola
ABSTRACT
Introduction: Enterobacteria have been acquiring antimicrobial resistance mechanisms, such as the production of extended spectrum beta lactamases (ESBL) thatgives resistance to several beta-lactams.These bacteria, capable of causing intrahospital and community infections difficult to treat, are spreading and inhabit environmental reservoirs, such as water; and is considered a public health problem. Unknown situation in our environment. Objective: Identify Enterobacteria producing BLEE and AmpC in water from the Tamborada and Rocha rivers, used for irrigation of crops in the Maica area of Cochabamba. Methods: Descriptive, cross-sectional and quantitative study. 70 water samples were analyzed: 44 from the Tamborada river and 26 from Rocha.The samples were grown in MacConkey Agar with Cefotaxime (2 μm/ml). Bacteria that grew were identified with chromogenic agar and biochemical tests.The ESBL and AmpC type producing strains were determined by diffusion and approximation of discs: Cefotaxime, Ceftazidime, Amoxicillin/Clavulanic acid for ESBL; and Cefoxitin for AmpC. Results: 23 strains of ESBL-producing Escherichia coli (32.8%) were isolated from the 70 samples. 22 of these isolates (resistant to cefoxitin) could also have AmpC resistance. Conclusion: E. coli producers of ESBL and probably AmpC are circulating in our environment such as waters of Rocha and Tamborada rivers, which represent a public health problem, more if we consider that these waters are used in irrigation of vegetables that they supply Cochabamba markets and can spread these bacteria among the population.
Keywords: Enterobacteriaceae, beta-Lactamases, waste water, agricultural irrigation
INTRODUCCIÓN
Las enterobacterias son habitantes normales de la flora bacteriana del intestino del hombre y los animales. Sin embargo, hoy se considera un problema de salud pública la diseminación y distribución de algunas enterobacterias que han adquirido mecanismos de resistencia a antimicrobianos empleados en el tratamiento de infecciones que pueden provocar. Un ejemplo es el de las bacterias productoras de BLEE, éstas son resistentes a betalactámicos como la penicilina, cefalosporinas de amplio espectro y un monobactámico como el aztreonam; también pueden ser resistentes a aminoglucósidos, trimetropim-sulfametoxazol y quinolonas1. Son sensibles a los carbapenémicos y por el reducido espectro de antimicrobianos útiles, hoy es un desafío la búsqueda de otras alternativas de tratamiento2.
A principios de 1980 se reportaron las primeras enterobacterias portadoras de BLEE, estas se aislaban exclusivamente en hospitales, primero en Europa y luego en otras partes del mundo3; 20 años más tarde, por el uso generalizado de cefalosporinas, emergieron infecciones adquiridas en la comunidad, principalmente como infecciones del tracto urinario4. En Guantao, China, encontraron estas bacterias en pozos de agua utilizados para riego y consumo humano5. En Holanda, se aislaron cepas de E. coli productora de BLEE a partir de muestras de aguas residuales (20 muestras), de plantas de tratamiento, por lo que se llegó a la conclusión de que el ambiente acuático es un reservorio importante para estas bacterias6. En Túnez, se realizaron 2 investigaciones que demostraron la presencia y caracterizaron a enterobacterias productoras de BLEE en aguas de diferentes fuentes, mostrando mayor porcentaje en las provenientes de aguas residuales7,8. Estas aguas contaminadas con aguas residuales del municipio representan un riesgo para la salud pública, su uso en el riego de productos agrícolas y su posterior consumo humano tiene como consecuencia infecciones difíciles de tratar9. En otro estudio realizado en Filipinas, se aisló 13 cepas productoras de BLEE de 212 muestras tomadas de aguas para el riego (147 muestras), suelo (39 muestras) y vegetales (26 muestras) en granjas urbanas, y resistencia a diferentes antibióticos en muestras de agua (67,3%), suelo (56,4%) y vegetales (42,3%)10.
Considerando estos antecedentes y habiendo sido demostrado que la diseminación ambiental de enterobacterias productoras de BLEE y AmpC es un problema de salud global5,6,7,8,9, creemos que es importante identificar los posibles reservorios acuáticos en nuestra región. Para ello elegimos la zona Maica de Cercado-Cochabamba porque es uno de los principales usuarios de aguas servidas para riego de choclo y alfalfa11. Consumir estás verduras sin lavar puede producir graves enfermedades parasitarias y bacterianas. El alcantarillado está conectado directamente con el Río Rocha y el Río Tamborada, el 20% de los agricultores utiliza agua de río contaminado con aguas servidas en especial desde el mes de abril a octubre11. Esta práctica implicaría la producción de alimentos contaminados que son consumidos por la población cochabambina.
La presente investigación tiene como objetivo Identificar Enterobacterias productoras de BLEE y AmpC en las aguas de los ríos Tamborada y Rocha, que son utilizadas para riego de cultivos agrícolas en la zona Maica aledaña a la ciudad de Cochabamba.
MATERIALES Y MÉTODOS
El presente estudio es de tipo descriptivo, transversal y cuantitativo, el universo fueron las aguas de los ríos utilizados como fuentes de agua en la zona Maica (Río Tamborada y Río Rocha) cercanas a la planta de tratamiento de Albarrancho. Los criterios de inclusión fueron las zonas de los ríos que se utilizan para el riego de cultivo y los criterios de exclusión fueron las zonas de los ríos que no se utilizan para el riego. Durante el mes de Julio de 2018 se tomaron las muestras cada 80-100 m a lo largo de los ríos. Se recolectaron 70 muestras (26 muestras del Río Rocha y 44 del Río Tamborada) en envases de plástico estériles, las cuales fueron transportadas a 4°C en cajas isotérmicas (ver Figura 1). Se extrajo 50 ml de agua del río en cada envase; se emplearon 2 técnicas para la concentración de las bacterias: una consistió en la centrifugación de 5 ml del agua a 2000 revolución por minuto (r.p.m.) por 5 minutos, (en 50 muestras), y la otra técnica fue por enriquecimiento con 50 ml de caldo de enriquecimiento Cerebro Corazón (Difco) (en 20 muestras). Una vez concentradas las muestras se sembraron en Agar McConkey suplementado con Cefotaxima a 2 μm/ml, se incubaron a 37°C por 24 horas, las colonias que crecieron se consideraron resistentes a cefalosporinas de tercera generación.
Para la prueba de susceptibilidad antimicrobiana se empleó la técnica de Kirby-Bauer estandarizada por "Clinical and Laboratory Standards Institute" (CLSI)12. Las bacterias que crecieron en el agar McConkey con Cefotaxima, fueron suspendidas en solución fisiológica a una concentración de 1,5 x 108 bacterias /mL (McFarland de 0,5), y sembradas en Agar Mueller Hinton. Para determinar la producción de BLEE se siguió el método de Jarlier13,14, con discos Cefotaxima y Ceftazidima (30 μg) ubicados a ambos lados (25 mm) del disco de Amoxicilina y ácido clavulánico (20/10 μg), la formación de halos de inhibición con agrandamiento en la interface entre la cefalosporina y el inhibidor de beta-lactamasas (efecto huevo) indicaba la producción de BLEE. Para la determinación de Enterobacterias productoras de beta-Lactamasas AmpC codificadas por un plásmido (pAmpC), se empleó el disco de Cefoxitin, en cepas que dan un halo a < 14 mm (resistencia) se tiene la sospecha de AmpC codificada por un plásmido (si la cepa identificada es Escherichia coli). La identificación de las enterobacterias se realizó con baterías bioquímicas y siembra en agar cromogénico.
Las ilustraciones fueron creadas mediante Adobe Phothoshop®, el mapa fue obtenido en GoogleEarth® y la tabla fue creada en Microsoft Excel®.
RESULTADOS
En total se aislaron 23 (32,8% ) cepas de E. coli productora de BLEE a partir de las 70 muestras de aguas de riego provenientes de los Ríos Rocha y Tamborada , de las cuales 22 posiblemente tienen AmpC adicional.
De acuerdo a los métodos de concentración de agua que se emplearon tenemos los siguientes resultados: De las 50 muestras centrifugadas (Tabla 1) provenientes del Río Rocha (26 muestras) y Río Tamborada (24 muestras) se obtuvieron 3 cepas cefotaxima-resistentes, las cuales se identificaron como E. coli productoras de BLEE (6%), siendo 2 de ellas además resistentes a la cefoxitina (posibles productoras de beta-Lactamasas AmpC).
A partir de las 20 muestras procedentes del rio Tamborada y pre-enriquecidas con caldo de cultivo se aislaron 20 cepas cefotaxima-resistentes, en todas se identificó producción de BLEE y resistencia a cefoxitin (posible pAmpC) (100%) (ver Figura 3.). Todas las cepas fueron identificadas como Escherichia coli.
DISCUSIÓN
En la presente investigación encontramos Escherichia coli productoras de BLEE y posiblemente AmpC en aguas de riego provenientes de los Ríos Rocha y Tamborada. Se aisló esta bacteria en 23 de las muestras estudiadas (32,8%), sin embargo, este porcentaje de aislamiento fue muy diferente de acuerdo al método de concentración empleado. Sólo hallamos E. coli BLEE en 3 (6%) de las 50 muestras concentradas por centrifugación, pero encontramos esta bacteria en las 20 (100%) muestras concentradas por enriquecimiento en caldo. Estos hallazgos concuerdan con otros estudios que han demostrado que el número de enterobacterias productoras de BLEE hallado, varía dependiendo del lugar y método empleado. Algunos investigadores utilizaron filtración por membranas para concentrar bacterias, este es un método de concentración que podría ser comparable al de centrifugación que empleamos en el presente trabajo. Con esta técnica Zhang y col. encontraron enterobacterias BLEE en 5 (16,7%) de 30 reservorios de agua rurales muestreados en China5, hallazgo comparable con el valor de 6% hallado en aguas de los ríos Rocha y Tamborada. En otra investigación realizada en Túnez, se utilizó el caldo de cultivo de peptona amortiguada, obteniendo un total de 24 (42,1 %) cepas productoras de BLEE y 4 productoras de AmpC de 57 muestras7. En la presente investigación, usando caldo cerebro corazón se obtuvo 20 cepas (100%) productoras de BLEE y posibles productoras beta-Lactamasas y AmpC codificadas por un plásmido.
Nuestros resultados también concuerdan con los encontrados en una investigación realizada en Holanda, en la que se estudiaron 20 muestras de agua superficial de cuatro regiones de los Países Bajos (incluidos ríos, canales, lagos, Mar del Norte); 20 muestras de aguas residuales incluidos influentes y efluentes de plantas de tratamiento de aguas residuales (de aeropuerto internacional y de las aguas residuales de las instituciones de salud) y se estableció que el ambiente acuático es un reservorio importante de bacterias E. coli productoras de BLEE y multiresistentes a diversos antimicrobianos, siendo esto un riesgo de salud para el hombre6. Cabe considerar que, aunque el área geográfica de la presente investigación es reducida en comparación al estudio de Holanda, si permitió demostrar que tenemos un importante reservorio de las bacterias mencionadas.
Ben Said L. y colaboradores7, estudiaron más a fondo una correlación de las fuentes de estas enterobacterias productoras de BLEE, analizando no solo agua, sino también suelo y vegetales. Se estudiaron 109 muestras de 18 granjas diferentes; se detectaron enterobacterias productoras de BLEE en 10 (9,2%) de las 109 muestras (4 de 49 de alimentos-vegetales, 3 de 41 muestras del suelo y 3 de 19 muestras de agua de riego). Las especies identificadas fueron: 6 de E. coli, 2 de Citrobacter feundii y 2 de Klebsiella pneumoniae, a diferencia de la presente investigación en la que sólo se encontró Escherichia coli. Al mismo tiempo otros investigadores, en el mismo país encontraron E. coli (18), C. freundii (1), K. pneumoniae (1) productoras de BLEE y E. coli productoras de beta-Lactamasas de AmpC en 57 muestras de aguas residuales8.
El estudio de aguas superficiales y residuales, realizado en Holanda, demostró que la probabilidad de encontrar Escherichia coli productora de BLEE incrementa por la presencia de aguas residuales9. Por lo tanto, deducimos que la presencia de enterobacterias productoras de BLEE en los Ríos Tamborada y Rocha puede deberse a que estos se encuentran contaminados con aguas residuales provenientes de la ciudad de Cochabamba y el aeropuerto Jorge Wilsterman.
En otros países ya se está monitoreando la epidemiologia de estas bacterias. Por ejemplo, se ha determinado que en el norte de Europa, así como en España y Portugal hubo un incremento en E. coli productor de BLEE, de un 0,2% a 2%15. En nuestra ciudad no tenemos información anterior a la del presente trabajo por lo que la epidemiología sobre estas bacterias no está muy clara.
En conclusión, las aguas de los Ríos Rocha y Tamborada son un reservorio de cepas de Escherichia coli productoras de Beta-lactamasas de espectro extendido (BLEE) y con posible mecanismo de resistencia de tipo AmpC plasmidial. Estas bacterias se han distribuido en el medio ambiente, saliendo de los hospitales, casas y diferentes partes de la ciudad, pasando por el alcantarillado que vierte sus aguas residuales en los ríos Rocha y Tamborada, cuyas aguas son utilizadas en el riego agrícola de los cultivos en la Zona Maica (Figura 2). El hallazgo de estas Enterobacterias productoras de BLEE en aguas de ríos empleadas en la actividad agrícola, representa un riesgo de salud pública, debido a que pueden contaminar alimentos que son enviados a mercados de abasto de la ciudad de Cochabamba y por lo tanto estarían propagando bacterias que no sólo van a dar problemas en cuanto a tratamiento si causan enfermedades infecciosas, si no que pueden ser fuente de diseminación de mecanismos de resistencia antimicrobiana a otras especies bacterianas.
En cuanto a la metodología para investigar bacterias productoras de BLEE en aguas, se recomienda pre-enriquecer las muestras con caldo cerebro corazón ya que permitiría una mayor multiplicación de las bacterias en la muestra mejorando su aislamiento en los agares convencionales, a diferencia de la centrifugación que permitió una menor concentración de las bacterias estudiadas.
AGRADECIMIENTOS
Un especial agradecimiento a la Dra. Gabriela Zamorano, bacterióloga del laboratorio PlusMed, por la orientación y apoyo en el procedimiento y análisis de la muestra, los auxiliares de bacteriología por la paciencia que tuvieron durante el soporte de investigación.
REFERENCIAS
1. Rodríguez J, Navarro M, Romero L, Martínez L, Muniain M, Perea E, et al. Epidemiology and Clinical Features of Infections Caused by Extended-Spectrum Beta-Lactamase-Producing Escherichia coli in Nonhospitalized Patients. J Clin Microbiol; [on line] Mar 2004 [Fecha de acceso: 4 de septiembre de 2018] 42 (3): 1089-94. Disponible en: DOI: https://doi.org/10.1128/JCM.42.3.1089-1094.2004
2. Rodríguez J. Carbapenems for 1 ESBL-producing Enterobacteriaceae: “The times they are a-Changing”. Antimicrob Agents Chemother. [on line] 2015 [Fecha de acceso: 7 de septiembre de 2018] 59: 5095–6. Disponible en: DOI: https://doi.org/10.1128/AAC.01333-15
3. Knothe H., Shah P. Krcmery V, Antal M, Mitsuhashi S. Transferable resistance to cefotaxime, cefoxitin, cefamandole an cefuroxie in clinical isolates of Klebsiella pneumonie and Serratia marcenscens. Infection. [on line] 1983. [Fecha de acceso: 7 de Julio de 2019] 11(6):315-317. Disponible en: DOI: https://doi.org/10.1007/BF01641355
4. Woerther PL, Buedet C, Chachaty E, Andremont A. Trends in Human Fecal Carriage of Extended-Spectrum B-Lactamases in the Community: Toward the Globalization of CTX-M. Clin Microbiol Rev. [on line] 2013. [Fecha de acceso: 7 de Julio de 2019] 26 (4): 744-757. Disponible en: DOI: 10.1128/CMR.00023-13.
5. Zhang H, Zhou Y, Guo S, Chang W. Multidrug resistance found in extended-spectrum beta-lactamase-producing Enterobacteriaceae from rural water reservoirs in Guantao, China. Front Microbiol [on line] Mar 2015, [Fecha de acceso: 10 de agosto de 2018] 6(267). Disponible en: DOI: https://doi.org/10.3389/fmicb.2015.00267
6. Franz E. Veenman C, van Hoek A.H, et al. Pathogenic Escherichia coli producing Extended-Spectrum β-Lactamases isolated from surface water and wastewater. Sci Rep [on line] 2015 [Fecha de acceso: 1 de agosto de 2018] 5, 14372. Disponible en: DOI: https://doi.org/10.1038/srep14372
7. Ben Said L, Jouini A, Klibi N, Dzirri R, Alonso C.A, Boudabous A, et al. Detection of extended-spectrum beta-lactamase (ESBL)-producing Enterobacteriaceae in vegetables, soil and water of the farm environment in Tunisia. Int J Food Microbiol [on line] June 2015, [Fecha de acceso: 26 de junio de 2018] 203: 86-92. Disponible en: DOI: https://doi.org/10.1016/j.ijfoodmicro.2015.02.023
8. Ben Said L, Jouini Ahlem, Alonso CA, et al. Characteristics of extended-spectrum β-lactamase (ESBL)- and pAmpC beta-lactamase-producing Enterobacteriaceae of water samples in Tunisia. Sci Total Environ. [on line] 2016 [Fecha de acceso: 26 de agosto de 2018] ; 550: 1103-09. Disponible en: DOI: https://doi.org/10.1016/j.scitotenv.2016.01.042
9. Blaak H, Lynch G, Italiaander R, Hamidjaja RA, Schets FM, de Roda Husman AM. Multidrug-Resistant and Extended Spectrum Beta-Lactamase-Producing Escherichia coli in Dutch Surface Water and Wastewater. PLoS One [on line] June 2015, [Fecha de acceso: 1 de septiembre de 2018] 10(6). Disponible en: DOI: https://doi.org/10.1371/journal.pone.0127752
10. Vital P, Zara E, Paraoan C, Dimasupil M, et al. Antibiotic Resistance and Extended-Spectrum Beta-Lactamase Production of Escherichia coli Isolated from Irrigation Waters in Selected Urban Farms in Metro Manila, Philippines. Water [on line] April 2018 [Fecha de acceso: 8 de Julio de 2019] 10(5):548. Disponible en: DOI: 10.3390/w10050548
11. Manzaneda L. El agua contaminada vuelve a la ciudad en productos agrícolas. Los Tiempos. [Internet] 28 Ago 2018 [Fecha de acceso: 2 de junio de 2019] Disponible en: https://www.lostiempos.com/actualidad/local/20170828/agua-contaminada-vuelve-ciudad-productos-agricolas
12. CSLI. Clinical and Laboratory Standars Institute. Performance Standards for Antimicrobial Susceptibility Testing. Twenty Eighth ed. Pennsylvania; 2018.
13. Jarlier V, Nicolas M, Fournier G, Philippon A. Extended broad-spectrum beta-lactamases conferring transferable resistance to newer beta-lactam agents in Enterobacteriaceae: hospital prevalence and susceptibility patterns. Rev Infect Dis [on line] 1988 [Fecha de acceso: 6 de septiembre de 2018] 10:867-78. Disponible en: DOI: https://doi.org/10.1093/clinids/10.4.867
14. Lezameta L, Gonzáles E, Tamariz J. Comparación de cuatro métodos fenotípicos para la detección de beta-lactamasas de espectro extendido. Rev Peru Med Exp Salud Pública [on line] 2010 [Fecha de acceso: 5 de mayo de 2019] 27(3): 345-51. Disponible en: https://www.scielosp.org/article/rpmesp/2010.v27n3/345-351/
15. Ghafourian S, Sadeghifard N, Soheili S, Sekawi Z. Extended Spectrum Beta-lactamases: Definition, Classification and Epidemiology. Curr Issues Mol Biol [on line] 2015 [Fecha de acceso: 8 de septiembre de 2018] 17:11-21. Disponible en: DOI: https://doi.org/10.21775/cimb.017.011